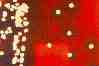

Les imatges que podeu veure a continuació són una petita
mostra d'allò que permet fer un equip com el que hem descrit. Cada
fotografia apareix reduïda, per què us en pugueu fer una primera
idea, seguida d'una breu descripció i de l'extensió i tipus
d'arxiu de la imatge completa. Si cliqueu sobre l'extensió de la imatge
podreu rebre l'arxiu complet, el qual en la majoria dels casos és tan
sols la fotografia, mentre que en alguns casos aquesta va associada a un seguit
d'informació útil per a interpretar-la.
Per poder observar correctament les imatges cal disposar d'un monitor
configurat, al menys, a 256 colors.
 |
Macrofotografia de Lemna minor 10.8
kb jpg |
 |
Macrofotografia de l'escut d'una moneda de cinc pessetes
28.6 kb jpg |
 |
Microfotografia de Daphnia magna 5.99
kb jpg |
 |
Macrofotografia d'un cultiu de Bacillus ssp
8.7 kb jpg |
 |
Microfotografia d'una preparació histològica d'epiteli de
ceba (Allium cepa)vista a 40 augments 16.5
kb jpg |
 |
Microfotografia de dues flors d'una inflorescència composta vistes a
40 augments 8.07 kb jpg |
 |
Microfotografia d'una preparació histològica d'epiteli amb
estomes vista a 40 augments 11.8 kb jpg |
 |
Microfotografia d'un cultiu en placa amb agar PDA d'un fong del gènere
Mucor 13.4 kb jpg |
 |
Microfotografia d'un tall histològic de tija de baladre (Nerium
oleander) vist amb 40 augments 16.7 kb
jpg |
 |
Macrofotografia de llavors de raïm 15.1
kb jpg |
 |
Macrofotografia d'un cultiu en medi diferencial de (Staphilococcus
ssp) 8.54 kb jpg |
 |
Macrofotografia d'un grup de flors de Violeta africana (Saintpaulina
ssp) 9.32 kb jpg |
 |
 Microfotografia d'un microfòssil
provinent d'un boci de Tripoli 11.8 kb jpg Microfotografia d'un microfòssil
provinent d'un boci de Tripoli 11.8 kb jpg |
 |
 Microfotografia de l'epidermis d'una fronda
de llentia d'aigua (Lemna minor) 5.3
k jpg Microfotografia de l'epidermis d'una fronda
de llentia d'aigua (Lemna minor) 5.3
k jpg |
 |
 Microfotografia de l'epidermis d'una fulla
de panis (Zea mais) 10.5 kb jpg Microfotografia de l'epidermis d'una fulla
de panis (Zea mais) 10.5 kb jpg |
 |
 Macrofotografia dels sorus d'una pinna
d'una falguera cultivada com a planta d'interior (Cyrtomium falcatum)
17.4 kb jpg Macrofotografia dels sorus d'una pinna
d'una falguera cultivada com a planta d'interior (Cyrtomium falcatum)
17.4 kb jpg |
 |
 Macrofotografia d'una infructescència
de girasol (Helianthus annuus) 14.6
kb jpg Macrofotografia d'una infructescència
de girasol (Helianthus annuus) 14.6
kb jpg |
 |
 Macrofotografia d'una infructescència
de l'escabiosa mossegada ( Scabiosa atropurpurea)
9.08 kb jpg Macrofotografia d'una infructescència
de l'escabiosa mossegada ( Scabiosa atropurpurea)
9.08 kb jpg |

Microfotografia d'un microfòssil
provinent d'un boci de Tripoli 11.8 kb jpg
Microfotografia d'un microfòssil
provinent d'un boci de Tripoli 11.8 kb jpg
 Microfotografia de l'epidermis d'una fronda
de llentia d'aigua (Lemna minor) 5.3
k jpg
Microfotografia de l'epidermis d'una fronda
de llentia d'aigua (Lemna minor) 5.3
k jpg
 Microfotografia de l'epidermis d'una fulla
de panis (Zea mais) 10.5 kb jpg
Microfotografia de l'epidermis d'una fulla
de panis (Zea mais) 10.5 kb jpg
 Macrofotografia dels sorus d'una pinna
d'una falguera cultivada com a planta d'interior (Cyrtomium falcatum)
17.4 kb jpg
Macrofotografia dels sorus d'una pinna
d'una falguera cultivada com a planta d'interior (Cyrtomium falcatum)
17.4 kb jpg
 Macrofotografia d'una infructescència
de girasol (Helianthus annuus) 14.6
kb jpg
Macrofotografia d'una infructescència
de girasol (Helianthus annuus) 14.6
kb jpg
 Macrofotografia d'una infructescència
de l'escabiosa mossegada ( Scabiosa atropurpurea)
9.08 kb jpg
Macrofotografia d'una infructescència
de l'escabiosa mossegada ( Scabiosa atropurpurea)
9.08 kb jpg